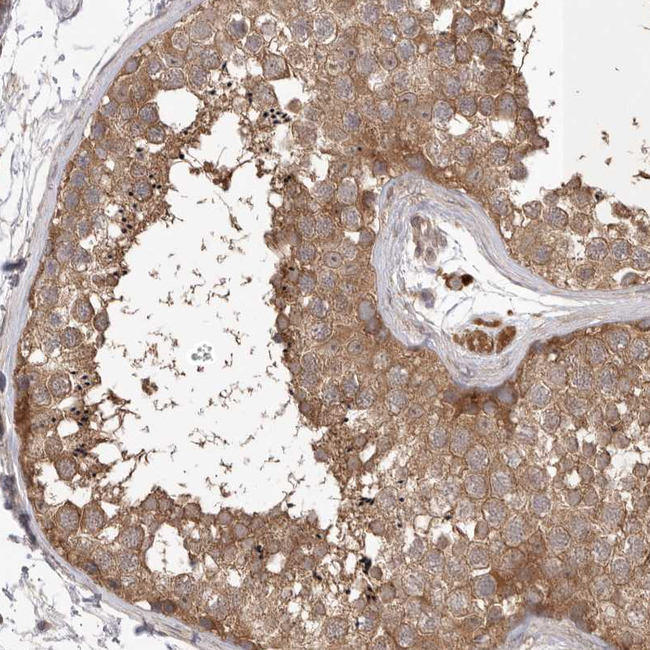
PRKAR1B Antibody in Immunohistochemistry (Paraffin) (IHC (P))

Search
Invitrogen
PRKAR1B Polyclonal Antibody
{{$productOrderCtrl.translations['antibody.pdp.commerceCard.promotion.promotions']}}
{{$productOrderCtrl.translations['antibody.pdp.commerceCard.promotion.viewpromo']}}
{{$productOrderCtrl.translations['antibody.pdp.commerceCard.promotion.promocode']}}: {{promo.promoCode}} {{promo.promoTitle}} {{promo.promoDescription}}. {{$productOrderCtrl.translations['antibody.pdp.commerceCard.promotion.learnmore']}}
产品信息
PA5-55392
种属反应
宿主/亚型
分类
类型
抗原
偶联物
形式
浓度
规格
纯化类型
保存液
内含物
保存条件
运输条件
RRID
产品详细信息
Immunogen sequence: QQVLKDCIVH LCISKPERPM KFLREHFEKL EKEENRQILA RQKSNSQSDS HDEEVSPT
Highest antigen sequence identity to the following orthologs: Mouse - 86%, Rat - 60%.
靶标信息
The second messenger cyclic AMP (cAMP) mediates diverse cellular responses to external signals such as proliferation, ion transport, regulation of metabolism and gene transcription by activation of the cAMP-dependent protein kinase (cAPK or PKA). Activation of PKA occurs when cAMP binds to the two regulatory subunits of the tetrameric PKA holoenzyme resulting in release of active catalytic subunits. Three catalytic (C) subunits have been identified that each represent specific gene products. Activation of transcription upon elevation of cAMP levels results from translocation of PKA to the nucleus where it phosphorylates the transcrip- tion factor cAMP response element binding protein (CREB) on serine 133 which in turn leads to TFIIB binding to TATA-box-binding protein TBP1, thus linking phospho-CREB to the pol II transcription initiation complex.
仅用于科研。不用于诊断过程。未经明确授权不得转售。
篇参考文献 (0)
生物信息学
蛋白别名: cAMP-dependent protein kinase type I-beta regulatory subunit; protein kinase, cAMP-dependent, regulatory subunit type I beta; protein kinase, cAMP-dependent, regulatory, type I, beta; unnamed protein product
基因别名: MASNS; PRKAR1; PRKAR1B
UniProt ID: (Human) P31321
Entrez Gene ID: (Human) 5575